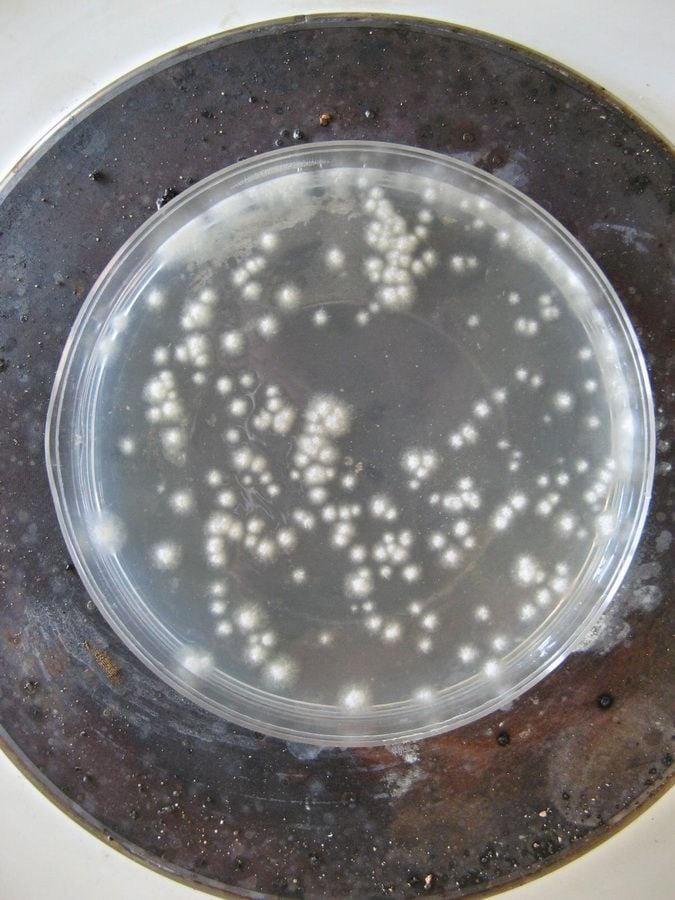

Állategészség védelem: A takarmány gombás eredetű szennyezettsége
Állati eredetű fehérjetakarmányokat (húsliszt, vegyes állati fehérjeliszt stb.) takarmányozási célra forgalomba hozni vagy felhasználni csak akkor szabad, ha a szalmonellaés lépfene-baktériumokra vonatkozó vizsgálat eredményei negatívak. Számítani kell arra, hogy technológiai hiba következtében a termék utólag fertőződik (pl. gümőkór, lépfene, szalmonella) vagy az importált takarmányféleségekben fordulnak elő olyan szalmonellatörzsek, amelyeket hazánkban korábban még nem mutattak ki.A takarmány gombás eredetű szennyezettségeA takarmányt a mindenütt jelen lévő penészgombák a szántóföldeken és raktárainkban állandóan szennyezik. A penészgomba-szennyezettség mértéke szorosan összefügg a növény fajtájával, a növény ellenálló képességével, a szántóföldi termesztési rendszerrel, az éghajlati tényezőkkel (csapadék, hőmérséklet, napfény, páratartalom stb.) és az alkalmazott betakarítási módszerekkel. Ez a szálas- és szemestakarmányokra, sőt bizonyos fokig az alomra is vonatkozik.A penészgombák kártételüket az alábbiak szerint fejtik ki:– a takarmány táplálóanyag- és egyéb biológiailag aktív vegyülettartalmát elbontják, csökkentik a táplálóértéket, íz- és szaghibát okoznak,– a penészgombák egyes anyagforgalmi termékei az állatokban károsítják az enzimrendszert, létfontosságú szervek működését, kedvezőtlenül változtathatják a bélcsatorna mikroflóráját,– jelentős azoknak a penészgombáknak a száma is, amelyek az emberre és állatra egyaránt mérgező toxinokat termelnek.A takarmányok penészesedése jelentős kárt okoz akkor is, ha a penészgombák anyagcseretermékei az állatokra teljesen ártalmatlanok, mert a takarmány táplálóértéke a penészgombák elszaporodása miatt csökken.
Hozzászólások (0)
Jelentkezz be, hogy hozzászólhass!
BejelentkezésMég nincs hozzászólás.
Legyél az első, aki hozzászól!